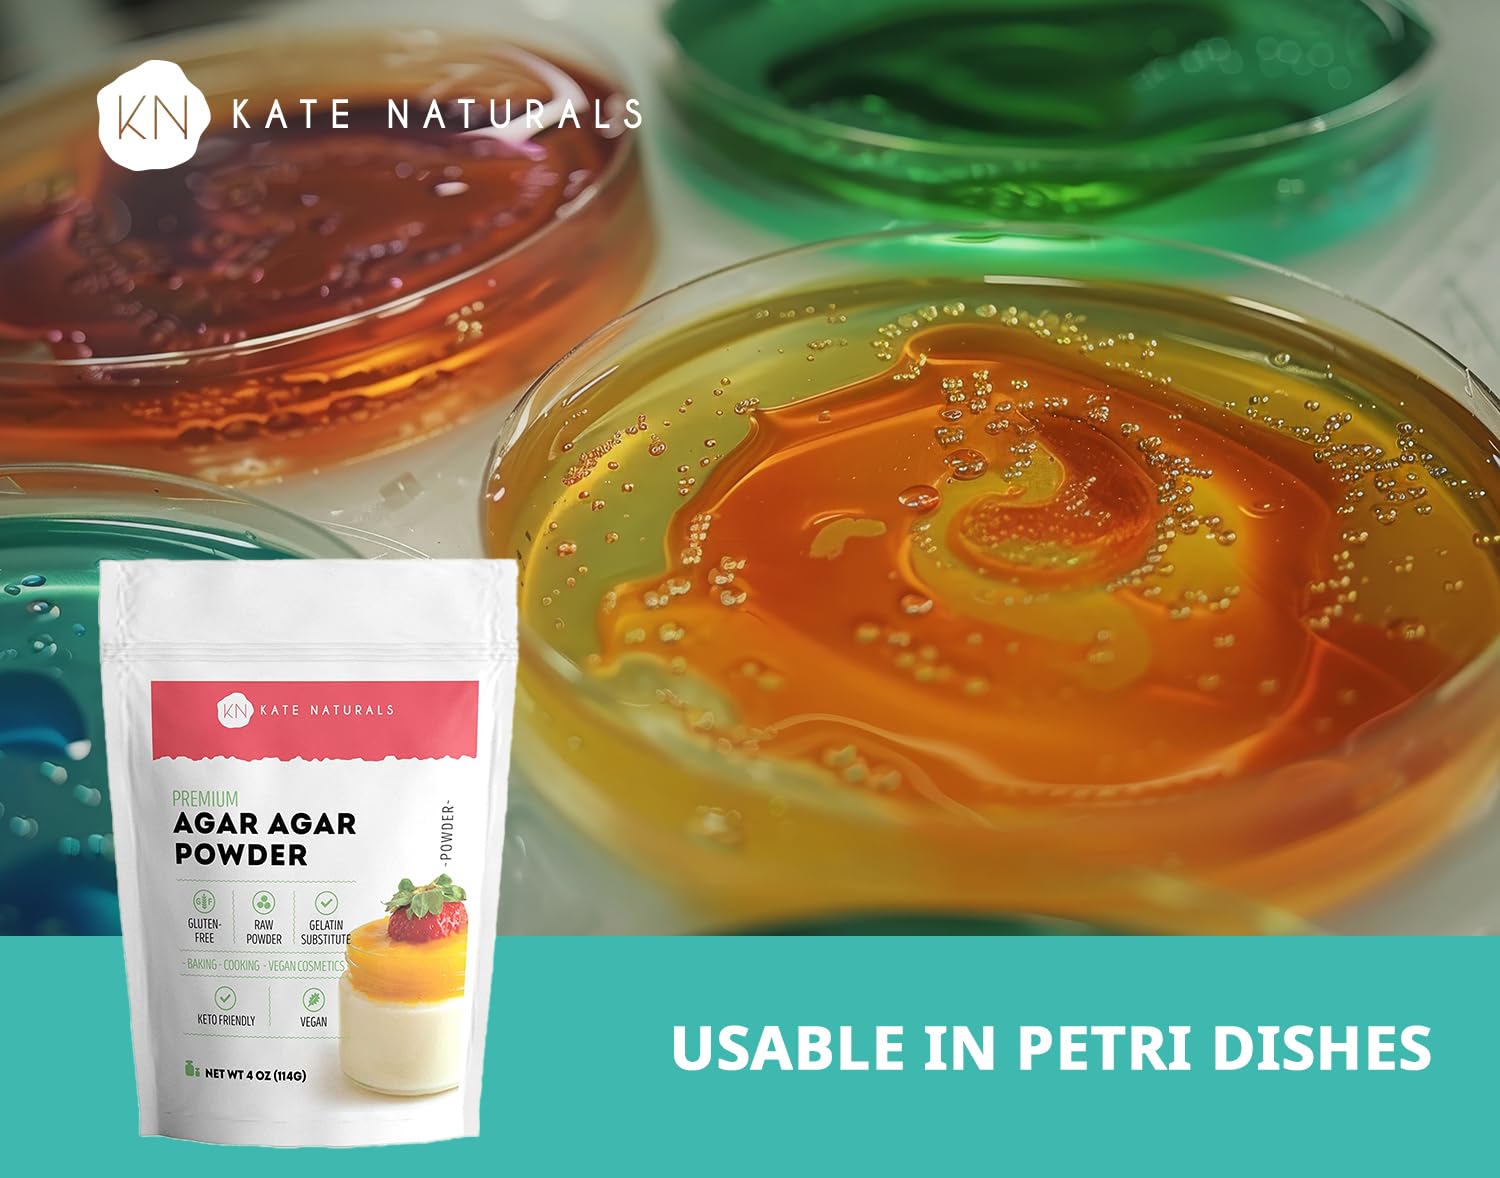

Kate Naturals Premium Agar Agar Powder 4oz
THICKENING AGENT: Perfect as a thickener for creamy soup, jelly, ice cream, candy, and gelatin recipes. It is a great ingredient for vegan cheese and food gelling agent. No odor. Can be used to strengthen and stabilize desserts.
GOOD FOR BONE HEALTH: In addition to calcium, Agar Agar is also high in manganese. Together these nutrients can help strengthen bones. As we age, we lose bone density so it’s important to maintain a healthy diet rich in calcium and manganese.
HIGH IN IRON AND FIBER: Agar Agar is high in iron and fiber. It can be difficult for those who consume a vegan diet to find good sources of iron. Adding Agar Agar to your diet can boost your iron intake and help your body produce healthy red blood cells.
VEGAN and KETO-FRIENDLY: Because Agar Agar is derived from seaweed and is sugar and carb free, it is both vegan and Keto-friendly. This highly versatile thickening agent that can be used in a number of different Keto and/or vegan recipes.
QUALITY GUARANTEE: We know you’ll love our healthy and natural Agar Agar powder but if you are not completely satisfied, let us know and we’ll make it right.
While the online sphere is replete with health stores, Health Synergy stands as a beacon of quality and sophistication. We pride ourselves on marrying ancient holistic traditions with cutting-edge scientific research. This harmonious blend ensures that our customers access products that are both timeless in efficacy and revolutionary in formulation. You can contact us directly should you have any questions, click here.
Should you inadvertently order the wrong item, Health Synergy gladly offers an exchange within 14 days of purchase, provided the product remains unopened and in its original condition. While we waive any restocking fees in such instances, customers will bear the return shipping costs and the shipping charges for the replacement item.
Choose options